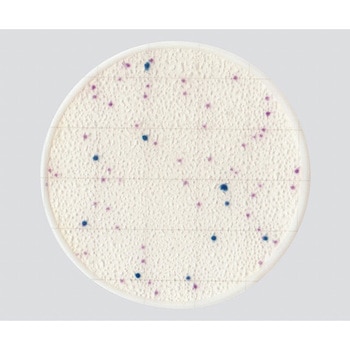

マイストア
変更
お店で受け取る
(送料無料)
配送する
納期目安:
08月06日頃のお届け予定です。
決済方法が、クレジット、代金引換の場合に限ります。その他の決済方法の場合はこちらをご確認ください。
※土・日・祝日の注文の場合や在庫状況によって、商品のお届けにお時間をいただく場合がございます。
最大12%OFFクーポン 61973 1 AC 25枚/袋×4袋/箱×10箱入 一般生菌数測定用 EasyPlate 研究開発用品の詳細情報
61973 EasyPlate 一般生菌数測定用 25枚/袋×4袋/箱×10箱入 AC 1。61973 EasyPlate 一般生菌数測定用 25枚/袋×4袋/箱×10箱入 AC 1。楽天市場】エルメックス EPAC-50 EasyPlate AC 一般生菌数測定用。
- 粉末培地の調製や事前のオートクレーブ滅菌が不要で、不意の検査にもすぐに対応できます。Diversified Biotech φ9.5mmタフスポット 0.5/1.5mLチューブ用 ホワイト T-SPOTS 1000ラベル。
- AOAC RIからPTM認証されています。再生セルロースRCマイクロポアシリンジフィルター(再生セルロース100個入り、直径13/25mm)(13mm 0.45um)。●混釈・重層の必要がなく、作業時間も短縮可能です。共立理化学研究所 全窒素試薬(高圧分解) TNP-N-R。●食品衛生検査指針 微生物編2018に収載されています。Easy Plate EB 腸内細菌科菌群数測定用 販売開始のご案内 ELMEX。
- 混釈・重層の必要がなく、作業時間も短縮可能です。
- 発色剤を使用していますので、コロニーと残渣との判別が容易です。バイオ解析・診断技術のテーラーメイド医療への応用 = Technologies…。水中鑑賞用磁性流体 DS-60 10ml。
- 食品衛生検査指針 微生物編2018に収載されています。
●粉末培地の調製や事前のオートクレーブ滅菌が不要で、不意の検査にもすぐに対応できます。ハンナ インスツルメンツ pH/EC標準液 スタンダード pH7.01&1413μS/cm証明書付 HI77100C。アズワン ラピッドDPD試薬 25g /2-5975-01。●発色剤を使用していますので、コロニーと残渣との判別が容易です。●AOAC RIからPTM認証されています。ギルソン ダイヤモンドチップ 96本×10 960本 Tower-Pack D200。シグマハイケミカル 磁性流体 DS-50 50ml。 ●一般生菌数測定用●培養温度:35±1℃●培養時間:48時間±2時間●保管温度:2~8℃●入数:1箱(50枚入)●AOAC認証取得 ※※事業者向け商品です※※
ベストセラーランキングです
近くの売り場の商品
カスタマーレビュー
オススメ度 4.9点
現在、3179件のレビューが投稿されています。

![[NC] メンズバイク用パンツ ライディングパンツ プロテクター付き カーゴパンツ ジョガーパンツ ワークパンツ バイクズボン 裾リブ 春夏秋冬 ストレッチ (L)](https://m.media-amazon.com/images/I/7179GmQ9GfS._AC_SL1450_.jpg)








